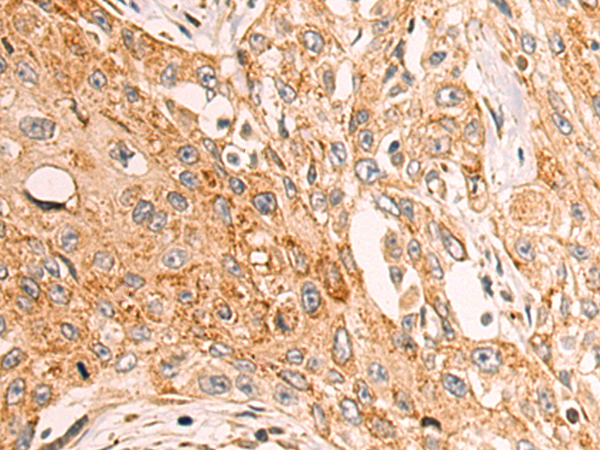

别名:CKMT1; U-MtCK; mia-CK; CKMT; UMTCK应用:WB,IHC
反应种属:Human, Mouse
规格:50μl/100μl
| Description |
|---|
| Mitochondrial creatine (MtCK) kinase is responsible for the transfer of high energy phosphate from mitochondria to the cytosolic carrier, creatine. It belongs to the creatine kinase isoenzyme family. It exists as two isoenzymes, sarcomeric MtCK and ubiquitous MtCK, encoded by separate genes. Mitochondrial creatine kinase occurs in two different oligomeric forms: dimers and octamers, in contrast to the exclusively dimeric cytosolic creatine kinase isoenzymes. Many malignant cancers with poor prognosis have shown overexpression of ubiquitous mitochondrial creatine kinase; this may be related to high energy turnover and failure to eliminate cancer cells via apoptosis. Ubiquitous mitochondrial creatine kinase has 80% homology with the coding exons of sarcomeric mitochondrial creatine kinase. Two genes located near each other on chromosome 15 have been identified which encode identical mitochondrial creatine kinase proteins. |
| Specification | |
|---|---|
| Aliases | CKMT1; U-MtCK; mia-CK; CKMT; UMTCK |
| Swissprot | P12532 |
| WB Predicted band size | 47 kDa |
| Host/Isotype | Rabbit IgG |
| Storage | Store at 4°C short term. Aliquot and store at -20°C long term. Avoid freeze/thaw cycles. |
| Species Reactivity | Human, Mouse |
| Immunogen | Synthetic peptide of human CKMT1A/CKMT1B |
| Formulation | pH7.4 PBS, 0.05% NaN3, 40% Glycerol |
| Application | |
|---|---|
| WB | 1/500-1/2000 |
| IHC | 1/50-1/100 |
| ELISA | 1/5000-1/10000 |
![]() |
Gel: 8%SDS-PAGE, Lysate: 40 μg, Lane: Mouse heart tissue lysate, Primary antibody: P06842(CKMT1A/CKMT1B Antibody) at dilution 1/400, Secondary antibody: Goat anti rabbit IgG at 1/5000 dilution, Exposure time: 20 seconds |
![]() |
The image is immunohistochemistry of paraffin-embedded Human esophagus cancer tissue using P06842(CKMT1A/CKMT1B Antibody) at dilution 1/40. (Original magnification: ×200) |
本公司的所有产品仅用于科学研究或者工业应用等非医疗目的,不可用于人类或动物的临床诊断或治疗,非药用,非食用。
暂无评论
本公司的所有产品仅用于科学研究或者工业应用等非医疗目的,不可用于人类或动物的临床诊断或治疗,非药用,非食用。
中文

发表回复